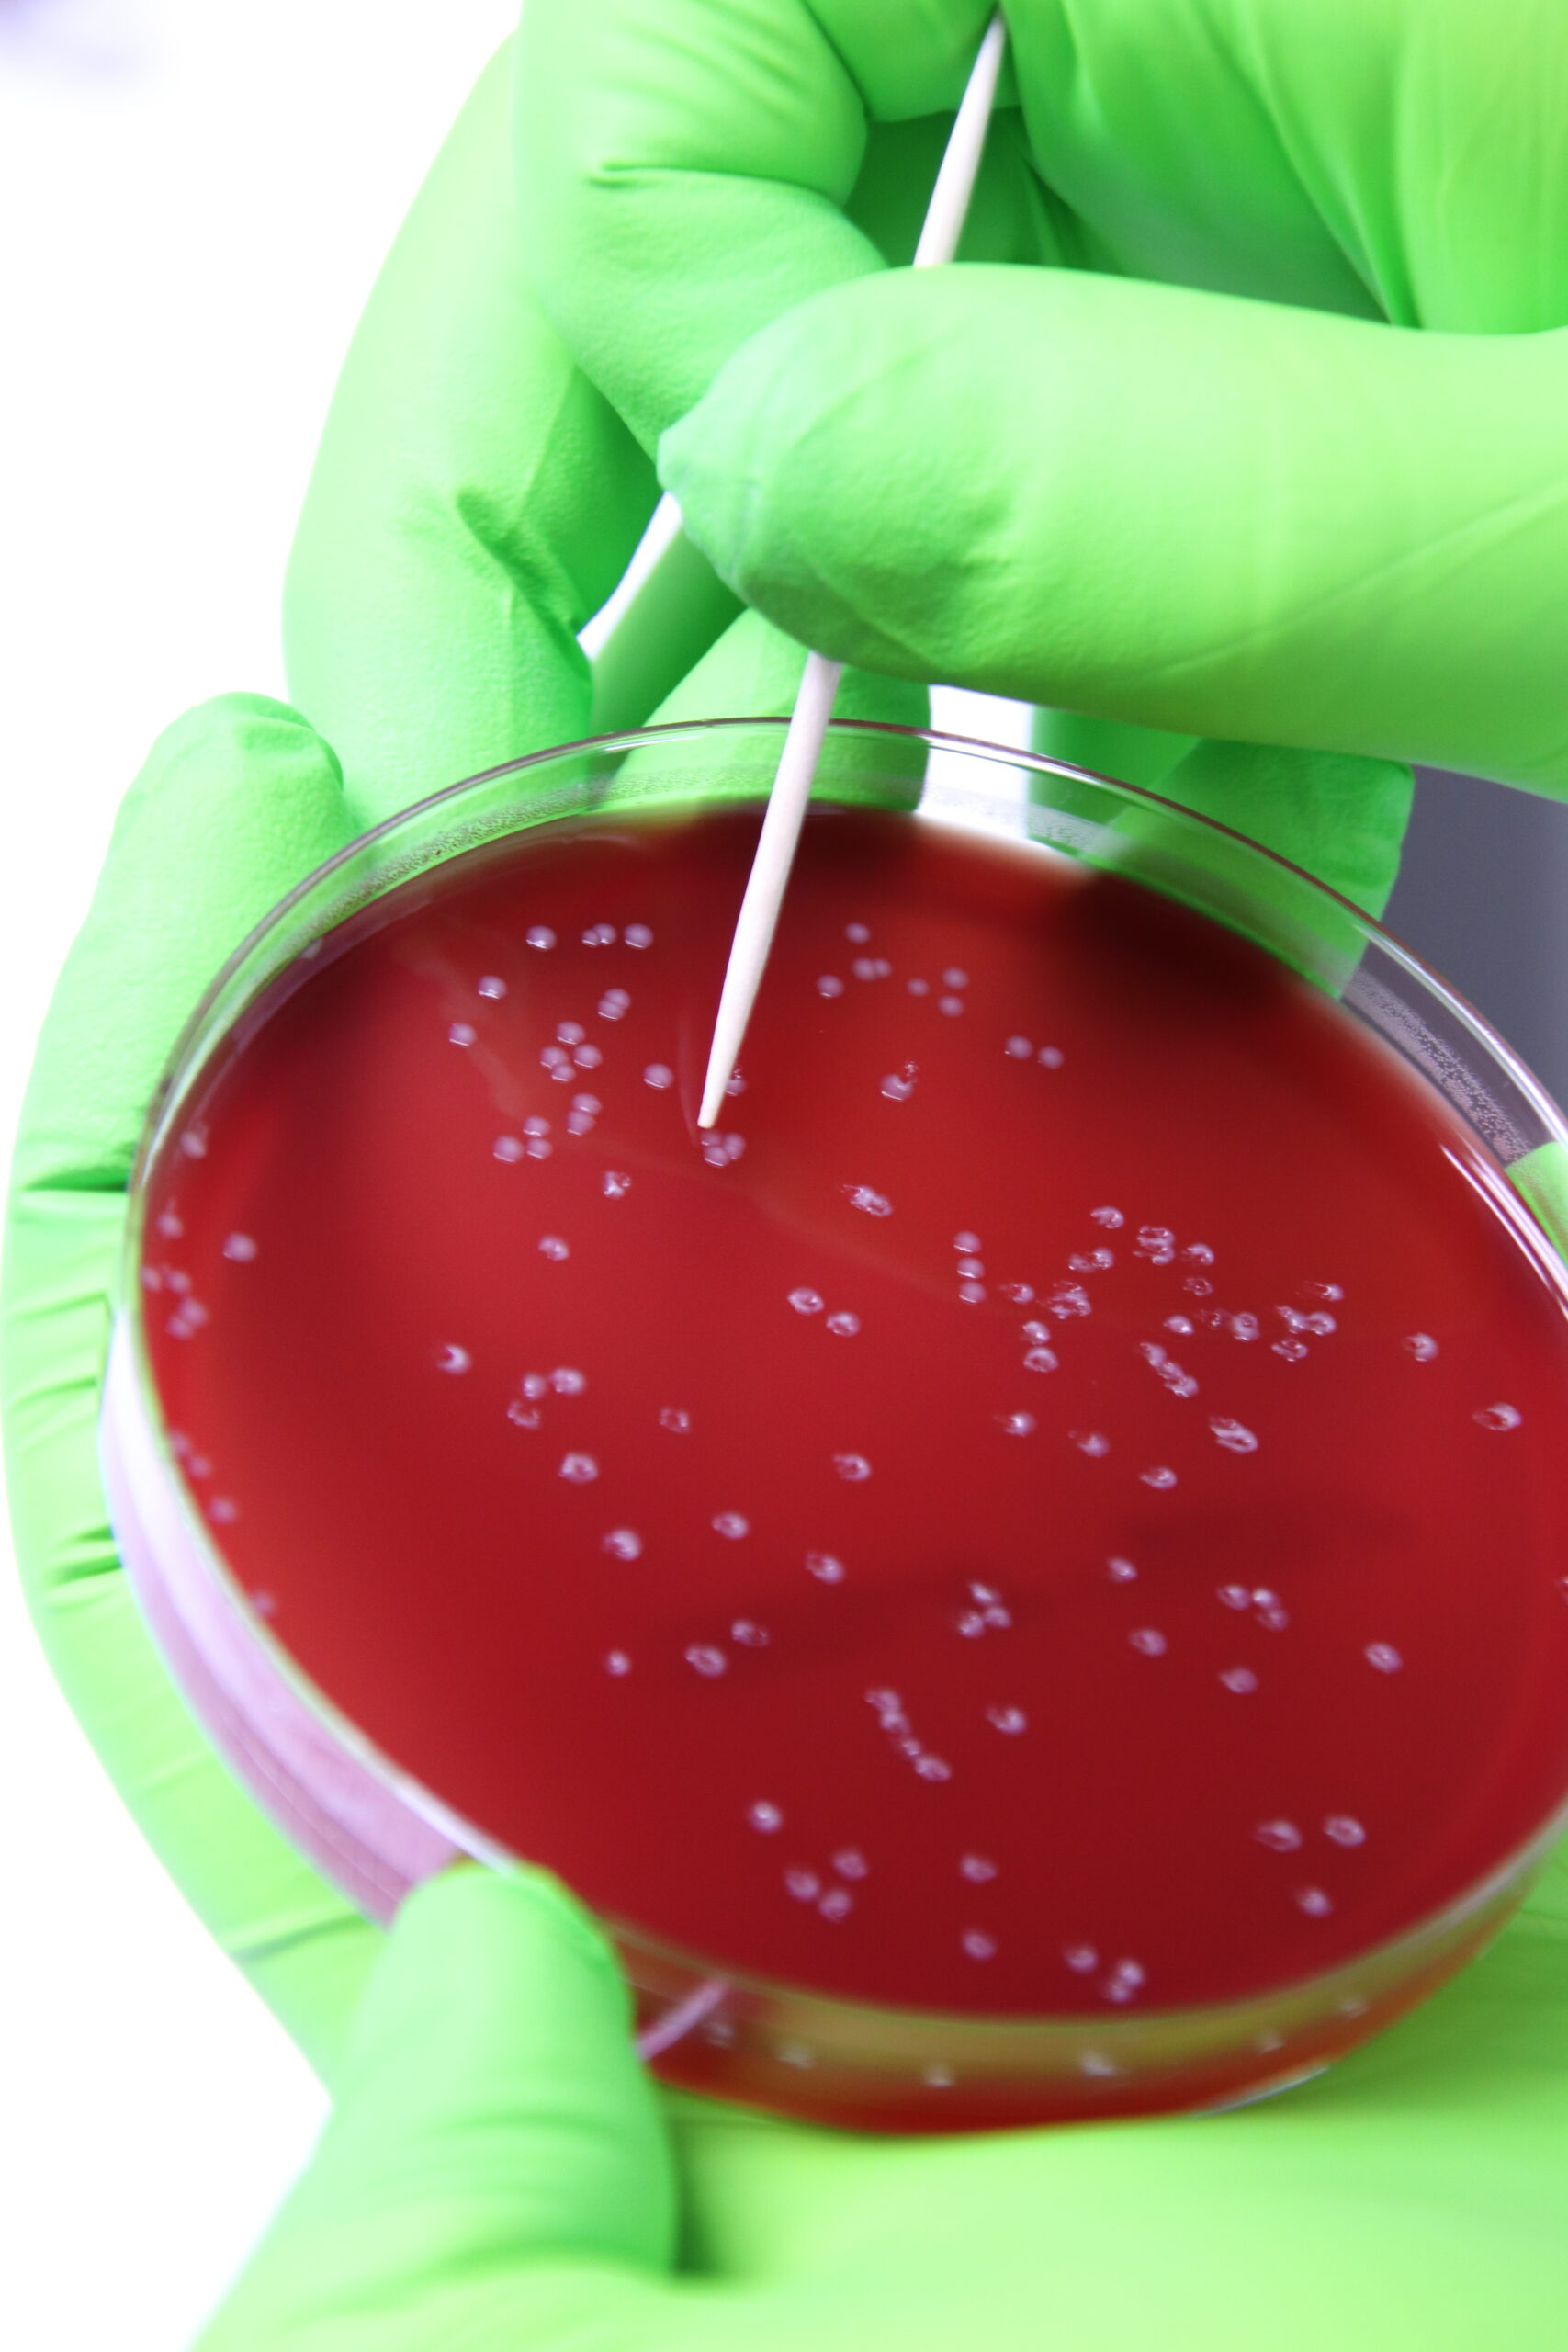

Diagnostics – Precise, Reliable, Actionable
Accurate diagnostics are the foundation of effective poultry health management. Poulpharm offers comprehensive diagnostic testing for bacteria, viruses, parasites and feed-related issues in poultry.
Our Diagnostic Capabilities Include
Bacteriology & mycology
(culture, identification, antibiotic sensitivity)
Virology & molecular diagnostics
(PCR, sequencing)
Serology
(ELISA, immunofluorescence)